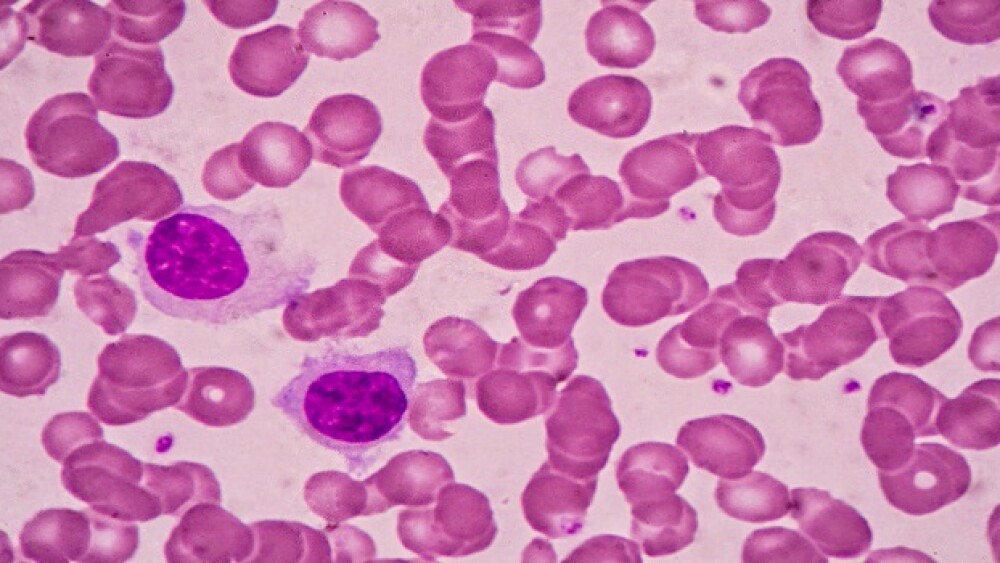

Horizon Pharma and the National Organization for Rare Disorders (NORD) launched a new campaign today that recognizes innovation in rare disease therapeutics since the passing of the Orphan Drug Act in 1983.
Horizon Pharma and the National Organization for Rare Disorders (NORD) launched a new campaign today that recognizes innovation in rare disease therapeutics since the passing of the Orphan Drug Act in 1983. Starting today, a display will be placed in the main lobby of the 2018 Biotechnology Innovation Organization (BIO) International Convention in Boston.
“The Orphan Drug Act has resulted in tremendous progress, with more than 600 orphan therapies having been FDA approved since its passing in 1983—compared with only 34 before that time,” said Peter Saltonstall, president and chief executive officer of NORD, in a statement. “With thousands of known rare diseases affecting 30 million Americans there is a great deal of work still to be done, and BIO is the perfect place to illustrate this unmet need as it pulls together innovators who thrive on finding solutions to challenges—rare diseases continue to be among the most daunting.”
Examples of recent movement in rare diseases including the U.S. Food and Drug Administration (FDA) approval of San Rafael, California-based BioMarin Pharmaceutical’s Palynziq (pegvaliase-pqpz) to treat phenylketonuria (PKU) in late May. The drug was approved to cut blood phenylalanine (Phe) concentrations in PKU patients who have uncontrolled Phe concentrations higher than 600 micromol/L who are already on treatment. PKU is a rare genetic disease. It is observed at birth and has a number of effects on the brain, which can cause seizures, and serious neurological and neuropsychiatric problems. Infants are screened at birth to guarantee an early diagnosis.
Japan-based Takeda Pharmaceutical is acquiring Dublin-based Shire for $62.2 billion. Shire’s focus is on rare diseases. It has drugs in its pipeline for Hunter IT, Metachromatic Leukodystrophy (MLD), HAE Prophylaxis, Alagille Syndrome, Progressive Familial Intrahepatic Cholestasis and numbers other rare diseases.
In late 2016, the FDA, after a lengthy, dramatic and controversial regulatory process, approved Sarepta Therapeutics’ Exondys 51 (eteplirsen) for Duchenne Muscular Dystrophy (DMD). DMD is a muscle wasting disease caused by mutations in the dystrophin gene. It is a progressive disease that causes death in early adulthood, with serious complications that include heart or respiratory-related problems. It mostly affects boys, about 1 in every 3,500 or 5,000 male children.
Rare diseases are often viewed favorably by biopharma companies because of their high prices, hence high margins. The Orphan Drug Act facilitated the development of orphan drugs for rare diseases. It recognizes, for example, that it may not be possible to evaluate 1,000 patients in a Phase III clinical trial, and accommodates smaller patient populations. There are also tax incentives, enhanced patent protection and marketing rights, and subsidies for clinical research.
In the U.S., a disease is dubbed “rare” if it affects less than 200,000 people. Other countries define it differently, often based on population. There are approximately 7,000 different rare diseases. Approximately five percent of those diseases have approved treatments.
“In addition to the six medicines we currently make available for rare diseases, we are rapidly growing our research and development team to accelerate the development of new medicines,” said Shao-Lee Lin, Horizon’s executive vice president, head of research and development and chief scientific officer, in a statement. “As we collectively strive to accelerate the progress made over the last 35 years, there is tremendous opportunity in our interactions at BIO with many of the brightest minds in rare disease and innovation.”
Attention 2018 BIO Conference attendees! Whether you’re a content-hungry life sciences professional or represent an organization looking for top talent, be sure to stop by the BioSpace booth during this event. Conveniently located near the entrance to the vendor space, booth number 2410 is the place to learn about everything BioSpace has to offer. Come talk to BioSpace CEO Josh Goodwin and Media Executive Melissa Nazzaro to talk about trends in the life sciences industry, pick up free BioSpace Hotbed map promo items, and learn how BioSpace can help you stay informed in a rapidly changing biotech landscape.
See you at booth 2410!